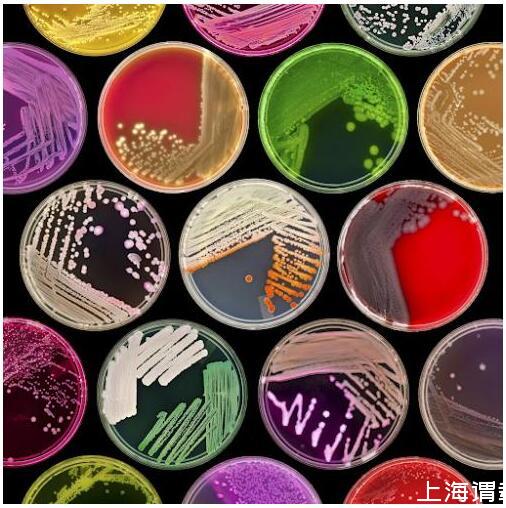

環境微生物之生長和繁殖
1.環境微生物的生長和繁殖
(1)環境微生物的生長:環境微生物在適宜的條件下,不斷從周圍環境中吸收營養物質,通過酶的作用轉化為細胞物質的組分和結構。同化作用的速度超過了異化作用,使個體細胞質量和體積增加的過程,稱為生長。
(2)環境微生物的繁殖:單細胞微生物,如細菌個體細胞增大是有限的,體積增大到一定程度就會分裂,分裂成兩個大小相似的子細胞,子細胞又重復上述過程,使細胞數目增加,稱為繁殖。
單細胞微生物的生長實際是以群體細胞數目的增加為標志的。霉菌和放線菌等絲狀微生物的生長主要表現為菌絲的伸長和分枝,其細胞數目的增加并不伴隨著個體數目的增多而增加。因此,其生長通常以菌絲的長度、體積及重量的增加來衡量,只有通過形成無性孢子或有性孢子使其個體數目增加才叫繁殖。
生長與繁殖的關系:
個體生長→個體繁殖→群體生長
群體生長=個體生長+個體繁殖
除特定的目的外,在微生物的研究和應用中僅有群體的生長才有實際意義,因此,在微生物學中提到的“生長”均指群體生長。

2.環境微生物生長的測定
(1)細胞數量的測定:
a.稀釋平板菌落計數法:
稀釋平板菌落計數法是一種最常用的活菌計數法。在大多數的研究和生產活動中,人們往往更需要了解活菌數的消長情況。從理論上講,在高度稀釋條件下每一個活的單細胞均能繁殖成一個菌落,因而可用培養的方法使每個活細胞生長成一個單獨的菌落,并通過長出的菌落數去推算菌懸液中的活菌數,因此菌落數就是待測樣品所含的活菌數。此法所得到的數值往往比直接法測定的數字小。
稀釋平板計數法類型:
(a)涂布法:涂布平板法是將一定體積樣品菌液稀釋后取一定量涂布于平板表面,在最適條件下培養后,從平板上出現的菌落數乘菌液的稀釋度,即可算出原菌液的含菌數。
(b)傾注法:傾注法是將經過滅菌冷卻至45-50℃的瓊脂培養基與稀釋后一定量的樣品在平皿中混勻,凝固后進行培養,然后進行計數。


稀釋平板計數法特點:
這種方法在操作時,有較高的技術要求。其中最重要的是應使樣品充分混勻,并讓每支移液管只能接觸一個稀釋度的菌液。
程序麻煩、費工費時,操作者需有熟練的技術。而且在混合微生物樣品中只能測定占優勢并能在供試培養基上生長的類群。

b.血球計數板法:
血球計數板是一塊特制的載玻片,計數是在計數室內進行的,即將一定稀釋度的細胞懸液加到固定體積的計數器小室內,在顯微鏡下觀測小室內細胞的個數,計算出樣品中細胞的濃度,稀釋濃度以記數室中的小格含有4-5個細胞為宜。由于計數室的體積是一定(0.1 mL)的,這樣可根據計數出來的數字,就可算出單位體積菌液內的菌體總數。但一般情況下,要取一定數量的計數室進行計數,在算出計數室的平均菌數后再次計算。

血球計數板法特點:
測定簡便、直接、快速,但測定的對象有一定的局限性,只適合于個體較大的微生物種類,如酵母菌、霉菌的孢子等。此外測定結果是微生物個體的總數,其中包括死亡的個體和存活的個體,要想測定活菌的個數,還須借助其他方法配合。
c.液體稀釋培養法:
對未知菌樣作連續10倍系列稀釋。根據估計數,從最適宜的3個連續10倍稀釋液中各取一定量的試樣,接種到裝有培養液的試管中。經培養后,記錄每個稀釋度出現生長的試管數,然后查MPN(Mostprobable number)表,再根據樣品的稀釋倍數就可算出其中的活菌量。該法常用于食品中微生物的檢測,如飲用水和牛奶的微生物限量檢查。

d.比濁法:
在細菌培養生長過程中,由于細胞數量增加,會引起培養物混濁度增高,使光線透過量降低。在一定濃度范圍內,懸液中細胞的數量與透光量成反比,與光密度成正比。比濁管是用不同濃度的BaCl2與稀H2SO4配制成的10支試管,其中形成的BaSO4有10個梯度,分別代表10個相對的細菌濃度(預先用相應的細菌測定)。某一未知濃度的菌液只需在透射光下用肉眼與某一比濁管進行比較,若兩者透光度相當,即可目測出該菌液的大致濃度。若要作精確測定可用分光光度計在可見光的450-650 nm波段內測定。

(2)細胞生物量的測定:
a.稱干重法:
即測定單位體積的培養物中細菌的干質量。該法要求培養物中無菌體外的固體顆粒,對單細胞及多細胞均適用。可用離心法或過濾法測定,一般菌體干重為濕重的10-20%。
在離心法中,將待測培養液放入離心管中,用清水離心洗滌1-5次后干燥。干燥溫度可采用105℃、100℃或紅外線烘干,也可在較低的溫度(80℃或40℃)下進行真空干燥后稱重。
在過濾法中,絲狀真菌可用濾紙過濾,而細菌則可用醋酸纖維膜等濾膜進行過濾。過濾后,細胞可用少量水洗滌,然后在40℃下真空干燥后稱干重。這種方法較適合于絲狀微生物的生長量的測定。

b.總氮量測定:
大多數細菌的含氮量為其干重的12.5%,酵母菌為7.5%,霉菌為6.0%。根據其含氮量再乘以6.25,即可測得粗蛋白的含量(其中包括雜環氮和氧化型氮),然后再換算成生物量。其中蛋白質總量=含氮量×6.25。細胞總量≈蛋白質總量×1.54。

c.DNA含量測定:
DNA在各種細胞內的含量最為穩定,不會因加入營養物而發生變化。盡管DNA測定方法較繁瑣、費用也高,但在某些特殊情況下,DNA測定可發揮其特殊的的優勢,如固定化載體內的微生物含量一般無法用直接法測定,但可將載體粉碎后測定DNA來估算微生物的細胞數。
核酸DNA是微生物的重要遺傳物質每個細菌的DNA含量相當恒定平均為8.4×10-5ng。

d.代謝活動法:
從細胞代謝產物來估算,在有氧發酵中,CO2是細胞代謝的產物,它與微生物生長密切相關。在全自動發酵罐中大多采用紅外線氣體分析儀來測定發酵產生的CO2量,進而估算出微生物的生長量。

3.環境微生物的生長規律
(1)微生物的生長曲線:
將少量單細胞微生物純菌種接種到新鮮的液體培養基中,在最適條件下培養,在培養過程中定時測定細胞數量,以細胞數的對數為縱坐標,時間為橫坐標,可畫出一條有規律的曲線,這就是微生物的生長曲線。生長曲線嚴格說應稱為繁殖曲線,因為單細胞微生物,如細菌等均以細菌數增加作為生長指標。這條曲線代表了細菌在新的適宜環境中生長繁殖至衰老死亡的動態變化。根據細菌生長繁殖速度的不同可將其分為四個時期:適應期、對數生長期、穩定期、衰亡期。

a.延滯期:又叫適應期,是微生物接種到新的培養基中,一般不立即進行繁殖,生長速率常數為零,需經一段時間自身調整,誘導合成必要的酶、輔酶或合成某些中間代謝產物。此時,細胞重量增加,體積增大,但不分裂繁殖,細胞長軸伸長(如巨大芽孢桿菌的長度由3.4μm增長到9.1-19.8μm),細胞質均勻,DNA含量高。細胞內RNA尤其是rRNA含量增高,原生質體嗜堿性。對外界不良條件的反應敏感。
在發酵工業,為提高生產效率,除了選擇合適的菌種外,常要采取措施縮短延滯期。其主要方法有:①以對數期的種子接種,因對數期的菌種生長代謝旺盛,繁殖力強,則子代培養期的適應期就短。②適當增加接種量。生產上接種量的多少是影響延滯期的的一個重要因素。接種量大,延滯期短,反之則長。一般采用3%-8%接種量,根據不同的微生物及生產具體情況而定,一般不超過1/10接種量。③培養基成分。現在發酵生產中,常用發酵培養的成分與種子培養基的成分相近。因為微生物生長在營養豐富的天然培養基中要比生長在營養單調的合成培養基中延滯期短。
b.對數生長期:又稱指數生長期,是在生長曲線中,緊接著延滯期后的一段時期。此時的菌體通過對新的環境適應后,細胞代謝活性最強,生長旺盛,分裂速度幾乎按幾何級數增加,群體形態與生理特征最一致,抵抗不良環境的能力最強。其生長曲線表現為一條近乎上升的直線。
在對數生長期,每一種微生物的世代時間(細胞每分裂一次所需要的時間)是一定的,這是微生物菌種的一個重要特征。以分裂增殖時間t除以分裂增殖代數(n),即可求出每增一代所需的時間(G)。
在一定時間內,菌體細胞分裂次數愈多,世代時間越短,分裂速度越快。不同微生物菌體其對數生長期中的世代時間不同,同一種微生物在不同培養基組分和不同環境條件下,如培養溫度、培養基pH值、營養物性質等,世代時間也不同。但每種微生物在一定條件下,其世代時間是相對穩定的。多數種類世代時間為20-30 min。

c.穩定期:又稱最高生長期。在一定溶劑的培養基中,由于微生物經對數生長期的旺盛生長后,某些營養物質被消耗,有害代謝產物積累以及pH值、氧化還原電位、無機離子濃度等變化,限制菌體繼續高速度增殖,初期細菌分裂間隔的時間開始延長,曲線上升逐漸緩慢。隨后,部分細胞停止分裂,少數細胞開始死亡,使新增殖的細胞數與老細胞死亡數幾乎相等,處于動態平衡,細菌數達到最高水平,接著死亡數超過新增殖數,曲線出現下降趨勢。這時,細胞內開始積累貯藏物質如肝糖原、異染顆粒、脂肪滴等,大多數芽孢細菌在此時形成芽孢。同時,發酵液中細菌的產物的積累逐漸增多,是發酵目的產物生成的重要階段(如抗生素等)。
d.衰亡期。穩定期后,環境變得不適合于細菌的生長,細胞生活力衰退,死亡率增加,以致細胞死亡數大大超過新生數,細菌總數急劇下降,這時期稱為衰亡期。這個時期細胞常出現多形態等畸形以及液泡,有許多菌在衰亡期后期常產生自溶現象,使工業生產中后處理過濾困難。產生衰亡期的原因主要是外界環境對繼續生長的細菌越來越不利,從而引起細菌細胞內的分解代謝大大超過合成代謝,導致菌體死亡。
(2)細菌的個體生長與同步生長:
在分批培養中,細菌群體以一定速率生長,但所有細胞并非同時進行分裂,即使培養中的細胞處于同一生長階段,它們的生理狀態和代謝活動也不完全一樣。要研究每個細胞所發生的變化是很困難的。為了解決這一問題,就必須設法使微生物群體處于同一發育階段,使群體和個體行為變得一致,所有的細胞都能同時分裂,因而發展了單細胞的同步培養技術。即設法使群體中的所有細胞盡可能都處于同樣細胞生長和分裂周期中,然后分析此群體的各種生物化學特征,從而了解單個細胞所發生的變化。
獲得細菌同步培養的方法主要有兩類,其一是通過調整環境條件來誘導同步性,如通過變換溫度、光線或對處于穩定期的培養物添加新鮮培養基等來誘導同步;其二是選擇法(又稱機械法),它是利用物理方法從不同步的細菌群體中選擇出同步的群體,一般可用過濾分離法或梯度離心法來達到。在這兩種方法中,由于誘導法可能導致與正常細胞循環周期不同的周期變化,所以不及選擇法好,這在生理學研究中尤其明顯。
在選擇法中,有代表性的是硝酸纖維素薄膜法。其大致過程為:將菌液通過裝有硝酸纖維素濾膜的過濾器,由于細菌與濾膜帶有不同的電荷,所以處于不同生長階段的細菌均附著在膜上;將膜翻轉,再用新鮮的培養液濾過培養;附著在膜上的細菌開始分裂,分裂的子細胞不能與薄膜直接接觸,由于菌體自身重量,加上其附帶的培養液重量,使菌體下落到收集器內;收集器在短時間內獲得的細菌都處于同一分裂階段的新細胞,用這些細胞接種培養,于是就獲得了同步生長。

(3)微生物連續培養:
連續培養又叫開放培養,是相對分批培養或密閉培養而言的。在分批培養中,培養基是一次性加入,不再補充,隨著微生物的生長繁殖活躍,營養物質逐漸消耗,有害代謝產物不斷積累,細菌的對數生長期不可能長時維持。連續培養是在研究生長曲線的基礎上,認識到穩定期到來的原因,采取在培養器中不斷補充新鮮營養物質,并攪拌均勻,同時不斷地以同樣速度排出培養物(包括菌體和代謝產物)。這樣,培養物就達動態平衡,其中的微生物可長期保持在對數期的平衡生長狀態和穩定的生長速率上。此法是目前發酵工業的發展方向。
微生物連續培養類型:
a.恒濁連續培養:用濁度計來檢測培養液中菌液濃度,使培養液中細菌的濃度恒定的培養方法稱為恒濁培養。所涉及的培養和控制裝置稱為恒濁器。當恒濁器中濁度超過預期數值時,可促使培養液流速加快,使濁度下降;濁度計低于預期數值時,流速減慢,使濁度增加。這種方法可自動地進行控制,使培養物維持一定的濁度。濁度下降,表明體系中有豐富營養物質,濁度的改變是培養物中的菌體數量的標志。
在恒濁器中通過控制培養液的流速,從而獲得密度高、生長速度恒定的微生物細胞的連續培養液。微生物在恒濁器中,始終能以最高生長速率進行生長,并可在允許范圍內控制不同的菌體密度。在生產實踐上,為了獲得大量菌體或與菌體生長相平行的某些代謝產物如乳酸、乙醇時,可采用恒濁法。
b.恒化連續培養:控制恒定的流速,使培養器內營養物質的濃度基本恒定,使細菌生長所消耗的物質及時得到補充,從而維持細菌恒定的生長速率的一種連續培養方法稱為恒化培養。常用于實驗室研究。
當營養物濃度偏高時,并不影響微生物的生長速度,而當營養物濃度較低時,則影響菌體生長速度,且在一定范圍內生長速率與營養物濃度成正比關系。營養物質濃度的確定往往是將培養基中的一種微生物生長所必需的營養物控制在較低的濃度下,作為限制生長的因子(如氮源、碳源、無機鹽或其他生長因子等),其他營養物是過量的。通過控制生長因子的濃度,來保持菌體恒定的生長速率。
連續培養如用于發酵工業中,就稱為連續發酵。連續發酵與分批發酵相比有許多優點:①高效。它簡化了裝料、滅菌、出料、清洗發酵罐等許多單元操作,從而減少了非生產時間和提高了設備的利用率;②自控。便于利用各種儀表進行自動控制;③產品的質量較穩定;④節約了大量動力、人力、水和蒸氣,且使水、汽、電的負荷均勻合理。
連續培養或連續發酵也有一定的缺點。最主要的缺點是菌種易于退化,處于長期高速繁殖下的微生物,即使其自發突變率極低,也無法避免變異的發生,尤其易發生比原生產菌株生長速率更高、營養要求低和代謝產物少的負變類型。其次,易受雜菌污染,在長期運轉中,要保持各種設備無滲漏,尤其是通氣系統不出任何故障,是極其困難的。因此,連續培養是有時間限制的,一般可達數月至一到兩年。此外,在連續培養中,營養物質的利用率一般也低于分批培養。

4.影響環境微生物生長的因素
影響環境微生物生長的外界因素很多,除營養物質外,還有許多物理、化學因素。當環境條件改變在一定限度內,可引起環境微生物形態、生理、生長、繁殖等特征的改變;當環境條件的變化超過一定極限時,則導致環境微生物死亡。
影響環境微生物生長的環境因素主要是溫度、水、pH、氧氣等。
(1)溫度的影響
溫度是影響環境微生物生長繁殖最重要的因素之一。在一定溫度范圍內,機體的代謝活動與生長繁殖隨著溫度的上升而增加,當溫度上升到一定程度,開始對機體產生不利的影響,若再繼續升高,則細胞功能急劇下降以至死亡。與其他生物一樣,任何環境微生物的生長溫度盡管有高有低,但總有最低生長溫度、最適生長溫度和最高生長溫度,這就是生長溫度的三個基本點。
最低生長溫度是指環境微生物能進行繁殖的最低溫度界限。處于這種溫度條件下的環境微生物生長速率很低,若低于此溫度則生長完全停止。
最適生長溫度是指環境微生物分裂的世代時間最短或生長速率最高時的培養溫度。但是,同一環境微生物,不同的生理生化過程有著不同的最適溫度,即最適生長溫度并不等于生長量最高時的培養溫度,也不等于發酵速度最高時的培養溫度或累積代謝產物量最高時的培養溫度。因此,生產上要根據微生物不同生理代謝過程溫度的特點,采用分段式變溫培養或發酵。如嗜熱鏈球菌的最適生長溫度為37℃,最適發酵溫度為47℃,累積產物的最適溫度為37℃。
最高生長溫度是指微生物生長繁殖的最高溫度界限。在此溫度下,微生物細胞易于衰老和死亡。微生物所能適應的最高生長溫度與其細胞內酶的性質有關。如細胞色素氧化酶以及各種脫氫酶的最低破壞溫度常與該菌的最高生長溫度有關。
環境微生物的溫型:
環境微生物按其生長溫度范圍可分為低溫型微生物、中溫型微生物和高溫型微生物三類。
a.低溫型微生物,又稱嗜冷微生物。可在較低的溫度下生長。常分布在地球兩極地區的水域和土壤中。常見的產堿桿菌屬、假單胞菌屬、黃桿菌屬、微球菌屬等常使冷藏食品腐敗變質。有些肉類上的霉菌在負10℃仍能生長,如芽枝霉;熒光極毛菌可在負4℃生長,并造成冷凍食品腐敗變質。
低溫也能抑制微生物的生長。在0℃以下,菌體內的水分凍結,生化反應無法進行而停止生長。有些環境微生物在冰點下就會死亡,主要原因是細胞內水分變成了冰晶,造成細胞脫水或細胞膜的物理損傷。因此,生產上常用低溫保藏食品,各種食品的保藏溫度不同,分為寒冷溫度、冷藏溫度和凍藏溫度。
寒冷溫度:指在室溫(14-15℃)和冷藏溫度之間的溫度。嗜冷微生物在這一溫度范圍內生長較緩慢,保藏食品的有效期較短,一般僅適宜于保藏果蔬食品。
冷藏溫度:指在0-5℃之間的溫度。在這一溫度范圍內,微生物的代謝活動已顯著減弱,可用于儲存果蔬、魚肉、禽蛋、乳類等食品。
凍藏溫度:指低于0℃以下的溫度。在-18℃以下的溫度幾乎阻止所有環境微生物的生長。在凍藏溫度下可較長期地保藏食品。
b.中溫型微生物。絕大多數環境微生物屬于這一類。最適生長溫度在20-40℃之間,最低生長溫度10-20℃,最高生長溫度40-45℃。它們又可分為嗜室溫和嗜體溫性微生物。嗜體溫性微生物多為人及溫血動物的病原菌,它們生長的極限溫度范圍在10-45℃,最適生長溫度與其宿主體溫相近,在35-40℃之間,人體寄生菌為37℃左右。引起人和動物疾病的病原微生物、發酵工業應用的微生物菌種及導致食品原料和成品腐敗變質的環境微生物均屬于這一類群的微生物,如大腸桿菌和酵母菌。因此,它與食品工業的關系最為密切。
c.高溫型微生物。它們適于在45-50℃以上的溫度中生長,在自然界中的分布僅局限于某些地區,如溫泉、日照充足的土壤表層、堆肥、發酵飼料等腐爛有機物中,如堆肥中溫度可達60-70℃。能在55-70℃中生長的微生物有芽孢桿菌屬、梭狀芽孢桿菌、嗜熱脂肪芽孢桿菌、高溫放線菌屬、甲烷桿菌屬等;溫泉中的細菌;其次是鏈球菌屬和乳桿菌屬。有的可在近于100℃的高溫中生長。這類高溫型的微生物,給罐頭工業、發酵工業等帶來了一定難度。

高溫型微生物耐熱機理可能是菌體內的蛋白質和酶比中溫型的微生物更能抗熱,尤其蛋白質對熱更穩定;同時高溫型微生物的蛋白質合成機構—核糖體和其他成分對高溫抗性也較大;細胞膜中飽和脂肪酸含量高,它比不飽和脂肪酸可以形成更強的疏水鍵,因此可保持在高溫下的穩定性并具正常功能。


(2)水分和滲透壓的影響
水是環境微生物營養物質的溶劑,水分對維持環境微生物的正常生命活動是必不可少的。水在環境微生物細胞中有兩種存在形式:結合水和游離水。結合水與溶質或其他分子結合在一起,很難加以利用。游離水則可被環境微生物利用。
水分活度是用來表示環境微生物在天然環境和人為環境中實際利用游離水的含量,即在相同條件下,密閉容器內該溶液的蒸汽壓(p)與純水蒸汽壓(p0)之比,即Aw=p/p0。純水的Aw=1,各種環境微生物在Aw=0.63-0.99的培養條件下生長。
環境微生物必須在較高的Aw環境中生長繁殖,Aw太低時,微生物生長遲緩、代謝停止,甚至死亡。但不同的環境微生物生長的最適Aw不同,即最低的水分活性區域不同。

干燥環境(Aw<0.60-0.70)條件下,多數環境微生物代謝停止,處于休眠狀態,嚴重時引起脫水,蛋白質變性,甚至死亡,這是干燥條件能保存食品和物品,防止腐敗和霉變的原理,同時,這也是環境微生物菌體保藏技術的依據之一。不同環境微生物在不同生長期對干燥的抵抗能力不同。酵母菌失水后可保存數月;產莢膜的菌比不產莢膜的菌對干燥的抵抗力強;小型、厚壁細胞的微生物比長型、薄壁細胞的微生物抗干燥能力強;芽孢、孢子抗干燥的能力比營養細胞強。
影響環境微生物對干燥抵抗力的因素較多,干燥時溫度升高,微生物容易死亡,環境微生物在低溫下干燥時,抵抗力強,故干燥后存活的環境微生物若處于低溫下可用于保藏菌種;干燥的速度快,環境微生物抵抗力強,緩慢干燥時環境微生物易死亡;環境微生物在真空干燥時,在加保護劑(血清、血漿、肉湯、蛋白胨、脫脂牛乳)的菌懸液中,分裝在安瓿內,低溫下可保持長達數年甚至10 a的生命力。
細胞內溶質濃度與胞外溶質濃度(如0.85%NaCl溶液)相等時的狀態,稱為等滲狀態。
溶液的溶質濃度高于胞內溶質濃度,則稱為高滲溶液,能在此環境中生長的環境微生物,稱為耐高滲微生物。當溶質濃度很高時,細胞就會脫水,發生質壁分離,甚至死亡。鹽漬(5%-30%食鹽)和蜜餞(30%-80%糖)可抑制或殺死環境微生物,這是一些常用食品保存法的依據。
若溶液的溶質濃度低于胞內溶質濃度,則稱為低滲溶液,環境微生物在低滲溶液中,水分向胞內轉移,細胞膨脹,甚至脹破。這是低滲破碎細胞法(通常將洗凈并離心得到的菌體投入80倍預冷的(5×10)-4 M/LMgCl2溶液中,劇烈攪拌,使細胞內溶物釋放到溶液中)的原理。該方法對細胞壁較牢固的革蘭氏陽性菌不適用。

(3)pH的影響
環境微生物生長的pH值范圍極廣,一般在pH 2-8間,少數種類還可超出該范圍。不同的環境微生物均有其最適生長pH值和一定的pH范圍,即最高、最適與最低三個數值,在最適pH范圍內環境微生物生長繁殖速度快,在最低或最高pH值的環境中,環境微生物雖能生存和生長,但生長速率很緩慢且易死亡。一般霉菌能適應pH值范圍最大,酵母菌適應的范圍較小,細菌最小。
霉菌和酵母菌生長最適pH值都在5.0-6.0,而細菌的生長最適pH值在7.0左右。一些最適生長pH值偏于堿性范圍內微生物,有的是嗜堿性,稱嗜堿性微生物,如硝化菌、尿素分解菌、根瘤菌和放線菌等。有的不一定要在堿性條件下生活,但能耐較堿的條件,稱耐堿微生物,如若干鏈霉菌等。生長pH值偏于酸性范圍內的微生物也有兩類,一類是嗜酸微生物,如硫桿菌屬等,另一類是耐酸微生物,如乳酸桿菌、醋酸桿菌、許多腸桿菌和假單胞菌等。


同一種微生物在其不同的生長階段和不同的生理生化過程中,對pH值的要求也不同。在發酵工業中,控制pH值尤其重要,如Aspergillus niger在pH 2-2.5時有利于合成檸檬酸,當在pH 2.5-6.5時以菌體生長為主,而在pH 7.0時,則以合成草酸為主。丙酮丁醇梭菌在pH 5.5-7.0時以菌體生長為主,而在pH 4.3-5.3時才進行丙酮丁醇發酵。
環境微生物在其代謝過程中,細胞內的pH值相當穩定,一般均接近中性,以保護核酸穩定和酶活性;但環境微生物會改變環境的酸堿度,使培養基原始pH值變化。發生的原因:糖類和脂肪代謝產酸、蛋白質代謝產堿、其他物質代謝產生酸堿。一般隨著培養時間的延長,培養基會變得較酸,當碳氮比例高的培養基,如培養真菌的培養基,經培養后其pH值常會明顯下降,而碳氮比例低的培養基,如培養一般細菌的培養基,經培養后,其pH值常會明顯上升。

(4)氧的影響
氧氣對環境微生物的生命活動有著重要影響。按照微生物與氧氣的關系,可把它們分成好氧菌和厭氧菌兩大類。好氧菌中又分為專性好氧、兼性厭氧和微好氧菌;厭氧菌分為專性厭氧菌、耐氧菌。
a.專性好氧菌。要求必須在有分子氧的條件下才能生長,有完整的呼吸鏈,以分子氧作為最終氫受體,細胞有超氧化物歧化酶(SOD)和過氧化氫酶,絕大多數真菌和許多細菌均是專性好氧菌,如米曲霉、醋酸桿菌、熒光假單胞菌、枯草芽孢桿菌和蕈狀芽孢桿菌等。


b.微好氧菌。只能在較低的氧分壓(0.01-0.03×101k Pa,正常大氣壓為0.2×101kPa)下才能正常生長的微生物。也通過呼吸鏈以氧為最終氫受體而產能。如霍亂弧菌、一些氫單胞菌、擬桿菌屬和發酵單胞菌屬。
c.兼性厭氧菌。在有氧或無氧條件下均能生長,但有氧的情況下生長得更好;有氧時進行好氧呼吸產能,無氧時進行發酵或無氧呼吸產能;細胞含SOD和過氧化氫酶。許多酵母菌和許多細菌都是兼性厭氧菌。如釀酒酵母、大腸桿菌和普通變形桿菌等。
d.耐氧菌。一類可在分子氧存在時進行厭氧呼吸的厭氧菌,即它們的生長不需要氧,但分子氧存在對它也無毒害。它們不具有呼吸鏈,僅依靠專性發酵獲得能量。細胞內存在SOD和過氧化物酶,但沒有過氧化氫酶。一般乳酸菌多數是耐氧菌,如乳鏈球菌、乳酸乳桿菌、腸膜明串珠菌和糞鏈球菌等,乳酸菌以外的耐氧菌如雷氏丁酸桿菌。
e.專性厭氧菌。分子氧存在對它們有毒,即使是短期接觸空氣也會抑制其生長甚至死亡;在空氣或含10%CO2的空氣中,它們在固體或半固體培養基的表面上不能生長,只能在深層無氧或低氧化還原勢的環境下才能生長;其生命活動所需能量是通過發酵、無氧呼吸、循環光合磷酸化或甲烷發酵等提供;細胞內缺乏SOD和細胞色素氧化酶,大多數還缺乏過氧化氫酶。常見的厭氧菌有罐頭工業的腐敗菌如肉毒梭狀芽孢桿菌、嗜熱梭狀芽孢桿菌、擬桿菌屬、雙歧桿菌屬及各種光和細菌和產甲烷菌等。

